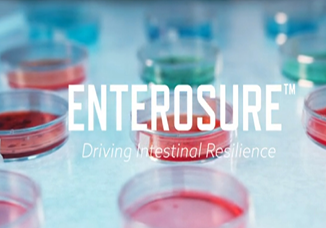
Updat-6

ENTEROSURE
Leaflet
Poultry producers face significant performance and economic challenges from the prevalent nature of enteric pathogens, as well as from multifaceted environmental factors.

ENTEROSURE Video
ENTEROSURE™ is a proprietary blend of probiotic Bacillus strains that secretes antimicrobial metabolites and quorum quenching molecules to directly inhibit and manage the growth of specific pathogenic bacteria and promote, restore and maintain a healthy microbiome, enabling the product to manage intestinal health challenges and improve animal productivity.